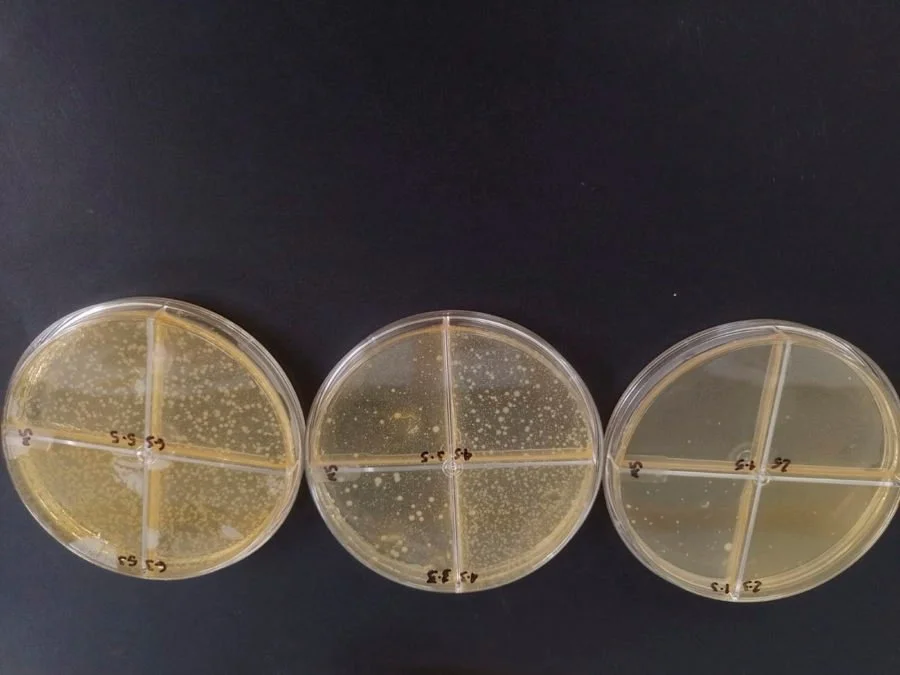
Proceso de fermentación en el laboratorio del ICTA para potenciar las bacterias benéficas en el desarrollo del Bioyogur

Agencia UNAL. Bogotá, 1 de marzo de 2023.
Se trata de Bioyogur, una bebida láctea que va camino a ser patentada gracias a que combina la pulpa de esta fruta y esta verdura para darle paso a un yogur sabroso, con antioxidantes que frenan el deterioro de las células y con fibra dietética que previene el estreñimiento. Unidos la zanahoria y el mango propician la proliferación de microorganismos (probióticos) que mejoran la flora intestinal y reducen el riesgo de obesidad.
Así, si usted es de los que le huye al consumo de verduras, con este innovador yogur no tendrá excusas para dejar de comerlas, pues su paladar será invadido por notas dulces, alimenticias, y que le ayudarán a su estómago a tener una mejor digestión, lidiar con la pesadez, la distensión, e incluso con el dolor abdominal.
El creador de Bioyogur es Ángel David Camargo, magíster en Ciencia y Tecnología de Alimentos de la Universidad Nacional de Colombia (UNAL), quien tomó la zanahoria y el mango –alimentos tropicales que en Colombia forman parte de la producción agrícola de zonas cálidas y templadas–, y los mezcló con la miel, en una leche natural.
Bioyogur es la denominación que puede recibir una bebida láctea como esta, que contiene probióticos y otros compuestos que resultan beneficiosos para la salud humana; así lo establece la Asociación Científica Internacional para Probióticos y Prebióticos (Isapp).
Los probióticos se obtienen en el proceso de fermentación y es por eso que se dice que el yogur es una fuente natural de estos microorganismos benéficos para la salud. En este desarrollo, el investigador incorporó probióticos comerciales para potenciar las bondades de la bebida láctea.
“En general, los yogures comerciales no tienen adición de probióticos, solo contienen los que se generan por la fermentación. En la legislación colombiana, y según parámetros internacionales, para tener el requisito de probiótico debe tener mínimo 106 unidades formadoras de colonias por mililitro (10⁶ UFC/mL), que indican el crecimiento de bacterias”.
Lo interesante es que Bioyogur obtuvo 10¹⁰ UFC/mL, una mayor presencia de estas bacterias que supera el rango mínimo establecido por la normatividad. Al contener una mayor carga de bacterias, aumenta su beneficio.
El resultado se logró tras llevar cuatro cepas comerciales con potencial probiótico al Laboratorio del Instituto de Ciencia y Tecnología de Alimentos (ICTA) de la UNAL, y se incluyeron en la leche de base previamente tratada en la planta de lácteos con la pulpa de la zanahoria y el mango.
Después se pasó a un proceso de refrigeración y almacenamiento a 4 °C durante 28 días, para validar el comportamiento de las bacterias. El día 21 el producto presentó un crecimiento significativo de dichos organismos.
El investigador resalta que “las 10¹⁰ UFC/mL de probióticos se mantuvieron vivas hasta el día 21, que fue el periodo que se determinó para hacer la evaluación, lo cual demostró que se pueden adaptar a bajas temperaturas”.
La zanahoria y el mango se eligieron por demostrar que favorecían la proliferación de los probióticos. Esto se determinó después de hacer pruebas con otra relación de alimentos como la ahuyama y el mango, que no presentaron resultados de tal nivel.
Y por supuesto, para evaluar la calidad del producto se recurrió a un grupo de “catadores” de yogur. Alrededor de 40 personas mayores de 16 años determinaron la aceptación del producto final luego de evaluar características como textura, sabor, apariencia y color. La mayoría de los comentarios coincidieron en señalar que era increíble pensar que dicho producto tenía como base la zanahoria.
La creación de Bioyogur fue co-dirigida por las profesoras Consuelo Díaz Moreno y Camila Bernal Castro, de la Facultad de Ciencias Agrarias de la UNAL. En 2022 ganó una convocatoria realizada en España por la Isapp en el marco del Congreso Anual, espacio para hablar de los beneficios de los probióticos y prebióticos en la salud, entre otros temas.